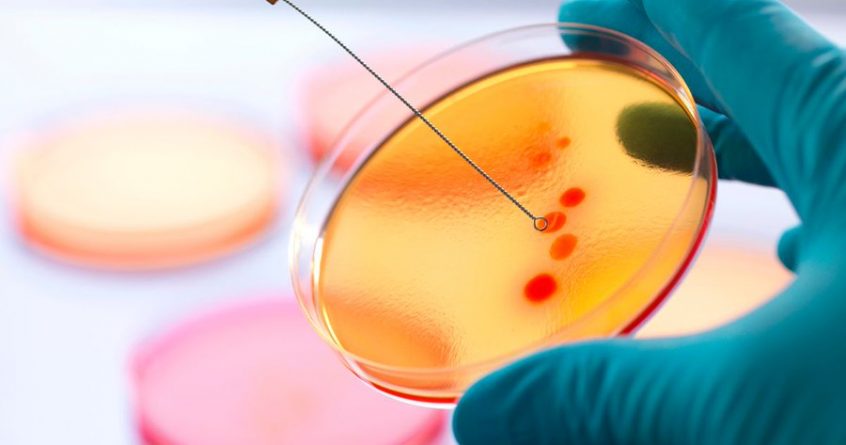

Antibiotic resistance could become the scourge of the human race. It’s already a serious threat to our health – it causes around 750,000 deaths a year and this number is predicted to rise to 10 million a year by 2050.
Every time a patient is treated with antibiotics there’s the possibility of resistance. Do we know how resistance emerges during infections, and if we did, could we stop it?
An international team led by Oxford University scientists has shown that bacteria interact with the immune system, shaping both the rise and fall of resistance during infection.
Moreover, our immune system appears to work with antibiotics to conquer bacterial infections.
Craig MacLean, co-author and professor of evolution and microbiology at the University of Oxford, said: “Our study suggests that natural immunity can prevent resistance during infection and stop the transmission of resistant strains between patients.
“Exploiting this link could help us to develop new therapeutics to use against bacterial pathogens and to better use antibiotics we have now.”
The researchers found antibiotics kill most of the bacteria causing an infection, but bacteria with resistant mutations would continue to multiply during treatment.
However, these mutants are weak so our immune system helps to suppress the infection, probably killing off more than 90% of resistant mutants that were present at the start of antibiotic treatment.
Furthermore, our immune system will also eventually eliminate the mutants present after treatment.
The team was able to illuminate the way our immune system deals with bacterial variants by delving down to an unprecedented level of detail to show how the immune system works. This research was made possible by bringing together many collaborators from leading academic research labs, along with AstraZeneca scientists.
This COMBACTE consortium is a major academia-industry collaboration exploring new approaches to bacterial resistance.
The harmful bacterium in this study was Pseudomonas aeruginosa, a nasty opportunistic bug that mainly causes infections in hospital patients and people with cystic fibrosis or bronchiectasis.
The work is part of a larger collaboration, the ASPIRE-ICU study, or Advanced understanding of Staphylococcus aureus and Pseudomonas aeruginosa Infections in EuRopE – Intensive Care Units.
Prof MacLean said: “This is the kind of study that I could have only dreamed of 10 years ago.
“Technological progress was certainly important to this project, but the real key to our success was increased collaboration and cross-talk between medical researchers and evolutionary biologists.”